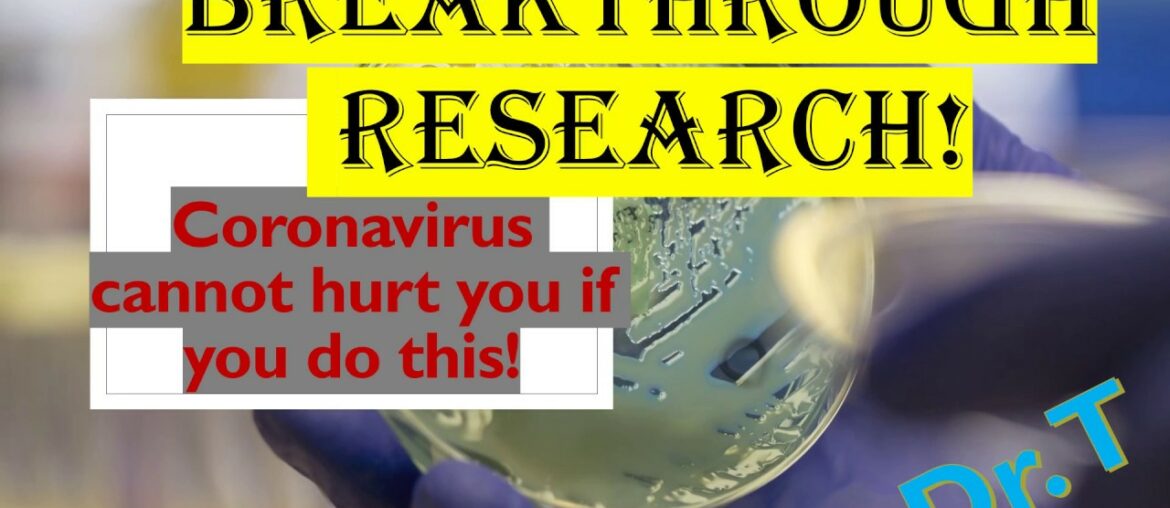
How to Treat Symptoms Of Coronavirus? | Viral Infection | Onestop Academy | Dr. T

Which Nutrition and Supplements are best for fat loss? Fitness Cravers Academy brings 2 days Online Live Web Workshop on “Fat loss & Supplementation”. Utilise it on yourself or on clients. Call 9650476019 & 8743056019 for registration. Hurry up! Fitness…